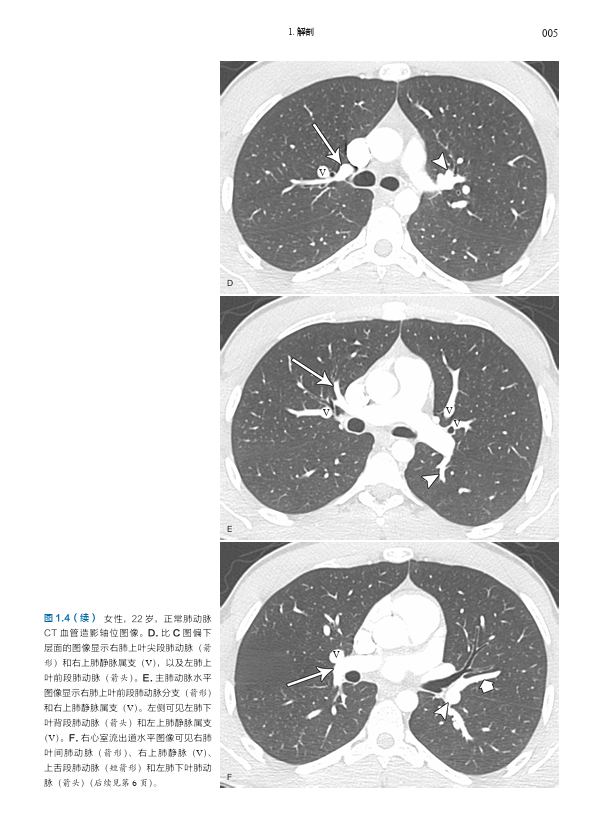

商品详情
书名:肺血管影像图谱
书号:978-7-5478-4972-9
定价:168元
作者:[美]康拉德·维特拉姆 著,曹云山 郭彦青 李宇 主译
译者简介:
曹云山,医学博士,哈佛大学医学院附属麻省总医院博士后,主任医师,博士研究生导师。现任甘肃省人民医院心内二科副主任。郭彦青,医学博士,副主任医师,博士研究生导师。现任甘肃省人民医院心内二科副主任。郭彦青,医学博士,副主任医师,现任山西省心血管病医院心内科十七病区(肺血管中心)主任。李宇,医学博士,主任医师,就职于首都医科大学附属北京安贞医院医学影像科。
内容提要:
本书是由哈佛大学医学院附属麻省总医院 Conrad Wittram 编写的有关肺血管疾病的综合影像图谱,内容包括肺血管正常解剖、先天性肺部疾病和心脏疾病的肺血管变化、特定类别的肺血管疾病(如栓塞、血栓形成、血管炎、动脉瘤和静脉瘤、感染、肿瘤、肺高血压等)、创伤与介入治疗相关肺血管问题,以及全身和肺部疾病的肺血管变化的影像学表现及特点。本书内容翔实,编排简明清晰,图文配合,每一页上都有详细的、清晰标记的高质量影像图,展示了 X 线片、血管造影、多层螺旋 CT、MRI、超声和核素显像等多种成像方式下的影像表现,配以绘图及指示性箭头等,使得影像特征更加清晰;文字精要,突出了最相关的重要信息。
目录:
1. 解剖 001
肺动脉 001
右肺动脉 009
左肺动脉 009
正常肺动脉直径 009
肺静脉 011
右肺静脉 011
左肺静脉 013
肺静脉解剖变异 013
支气管动脉 016
2. 先天异常 018
肺动脉缺如 018
肺动脉发育不全 020
肺动脉狭窄 022
左肺动脉吊带畸形 022
永存动脉干 023
肺动静脉畸形 024
体动脉供应正常肺组织 027
叶内型肺隔离症 027
叶外型肺隔离症 028
肺发育不良综合征(弯刀综合征) 029
支气管动静脉畸形 032
部分性肺静脉异位引流 032
完全性肺静脉异位引流 033
3. 心脏疾病 036
房间隔缺损 036
室间隔缺损 037
动脉导管未闭 039
急性肺静脉高压 041
慢性肺静脉高压 045
4. 栓塞 048
急性血栓性肺栓塞 CT 和肺动脉造影的直接征象 048
急性血栓性肺栓塞的间接征象 052
急性血栓性肺栓塞严重程度的 CT 评估 054
慢性血栓性肺栓塞 CT 和肺动脉造影的直接征象 055
慢性血栓性肺栓塞的间接征象 060
CT 误诊肺栓塞的原因 062
患者相关因素 062
技术因素 064
解剖因素 068
病理因素 070
CTPA 不能确定的情况 070
通气 - 灌注显像解读 072
肺栓塞磁共振成像 074
偶然发现的血栓性肺栓塞 074
非血栓性肺动脉栓塞 075
空气栓塞 075
导管栓塞 075
水泥(聚甲基丙烯酸甲酯)栓塞 075
金属汞栓塞 077
滑石粉栓塞 077
脂肪栓塞 079
硅胶栓塞 080
羊水栓塞 080
肿瘤栓塞 081
5. 原位血栓形成 083
肿瘤相关肺动脉血栓形成 083
放射治疗相关肺动脉血栓形成 084
肺动脉残端血栓形成 084
感染相关肺动脉血栓形成 085
血管炎相关肺动脉血栓形成 086
肺高血压与原位血栓形成 087
肺静脉血栓形成 088
CT 肺静脉血栓形成伪像 089
6. 动脉瘤和静脉瘤 091
梭状动脉瘤 091
囊状动脉瘤 091
狭窄后肺动脉扩张 092
肺动脉损伤 093
感染性动脉瘤 094
肿瘤性动脉瘤 095
血管炎性动脉瘤 095
肺高血压 096
特发性动脉瘤 096
支气管动脉瘤 097
肺静脉瘤(肺静脉曲张) 098
7. 血管炎 100
白塞综合征 100
Takayasu 动脉炎 101
巨细胞动脉炎 101
Wegener 肉芽肿 102
显微镜下多血管炎 104
Churg-Strauss 综合征 106
Goodpasture 综合征 107
冷球蛋白血症性血管炎 108
过敏性紫癜 108
系统性红斑狼疮 109
药物性血管炎 109
8. 感染 111
急性细菌感染 111
反复细菌感染 111
脓毒性栓塞 112
分枝杆菌感染 113
真菌感染 116
病毒感染 117
寄生虫感染 118
9. 创伤与介入治疗 120
假性动脉瘤 120
脂肪栓塞 120
空气栓塞 121
导管栓塞 121
骨水泥(聚甲基丙烯酸甲酯)栓塞 122
肺动脉血栓形成 123
肺静脉血栓形成 124
肺移植后肺血管狭窄 124
肺静脉消融治疗 125
肺动脉导管损伤 126
瘘 127
10. 肿瘤 129
原发性肉瘤 129
卡波西肉瘤 130
血管内淋巴瘤 131
上皮样血管内皮细胞瘤 132
转移性血管肿瘤 132
肿瘤栓塞 133
肺癌 133
放射疗法 136
11. 全身和肺部疾病 138
结节病 138
肝肺综合征 138
镰状细胞病 141
支气管肺发育不良 142
特发性肺含铁血黄素沉着症 143
肺气肿 144
肺朗格汉斯细胞组织细胞增多症 145
普通型间质性肺炎 146
淋巴管瘤病 147
毛细血管瘤病 149
肺静脉闭塞症 150
12. 肺动脉高压 152
原发性肺高血压 152
特发性肺动脉扩张 154
运动引起的肺出血 154
高原性肺水肿 155
专业术语汉英对照 157

- 医路优选 (微信公众号认证)
- 品种丰富的医学类书籍!
- 扫描二维码,访问我们的微信店铺
- 随时随地的购物、客服咨询、查询订单和物流...